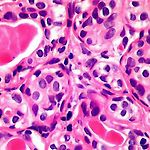

(주)지뉴인텍
 모든 암세포 공격 새로운 T세포 발견
모든 암세포 공격 새로운 T세포 발견
모든 암세포 공격 새로운 T세포 발견 영국 카디프대학교 앤드루 시웰 감염면역학 교수(왼쪽)와 게리 돌튼(Garry Dolton) 연구원 [헬스코리아뉴스 / 서정필] 기존 항암면역치료의 한계를 극복할 새로운 T-세포가 영국 연구진에 의해 발견됐다. 영국 카디프대학교(Cardiff University) 연구진은 최근 갈고리 모양을 가진 특이한 수용체를 통해 종류를 가리지 않고 거의 모든 암세포에 반응해 암세포를 공격하는 T세포를 발견했다. 연구팀이 암세포를 투여한 쥐를 대상으로 실험한 결과 이 세포는 정상 세포에는 아무런 반응을 하지 않으며 ▲폐암 ▲피부암 ▲혈액암 ▲대장암 ▲유방암 ▲뼈암 전립선암 ▲난소암 ▲신장암 ▲자궁암 세포 등 여러 암세포에 반응해 이 암세포들을 모두 없애는 것으로 관찰됐다. 이러한 ..
 새로운 T면역세포 발견…항암 면역치료에 돌파구?
새로운 T면역세포 발견…항암 면역치료에 돌파구?
새로운 T면v역세포 발견…항암 면역치료에 돌파구? 서울=연합뉴스) 한성간 기자 = 지금까지 학계에 전혀 알려지지 않은 새로운 T면역세포가 발견됐다. 영국 카디프대학 감염·면역연구소(Institute of Infection and Immunity) 연구실장 앤드루 시웰 교수 연구팀은 갈고리 모양의 특이한 수용체를 가지고 광범위한 암세포에 달라붙어 공격하는 전혀 새로운 유형의 T면역세포를 발견했다고 텔레그래프와 BBC 뉴스 인터넷판이 20일 보도했다. 이 T면역세포는 정상 세포는 건드리지 않으며 폐암, 피부암, 유방암, 혈액암, 전립선암, 대장암, 골수암, 난소암, 신장암, 자궁경부암 세포를 죽이는 것으로 시험관 시험에서 확인됐다고 연구팀은 밝혔다. 이 새로운 T면역세포는 박테리아와 싸울 수 있는 면역세포를..
모든 암세포를 박멸할 가능성이 있는 면역체계가 발견됐다
모든 암세포를 박멸할 가능성이 있는 면역체계가 발견됐다
모든 암세포를 박멸할 가능성이 있는 면역체계가 발견됐다 Image copyright Science Photo Library 이번에 발견된 새로운 방법은 유방암과 전립선암을 비롯한 다양한 종류의 암 치료에 모두 사용될 수 있다 새롭게 발견된 인간의 면역체계가 모든 암을 치료하는 데 적용될 수 있다고 과학자들은 말한다. 카디프대학교 연구진은 실험실에서 전립선암, 유방암, 폐암과 다른 종류의 암을 박멸하는 방법을 발견했다. '네이처 이뮤놀로지' 저널에 실린 이 새로운 방법은 아직까지 임상 실험을 거치진 않았으나 연구진은 "엄청난 잠재성"을 갖고 있다고 한다. 전문가들은 아직 연구 자체는 초기 단계에 있긴 하지만 매우 흥미롭다고 말했다. 연구진은 무엇을 발견했나? 면역체계란 우리가 세균 등에 감염됐을 때 발동하..
